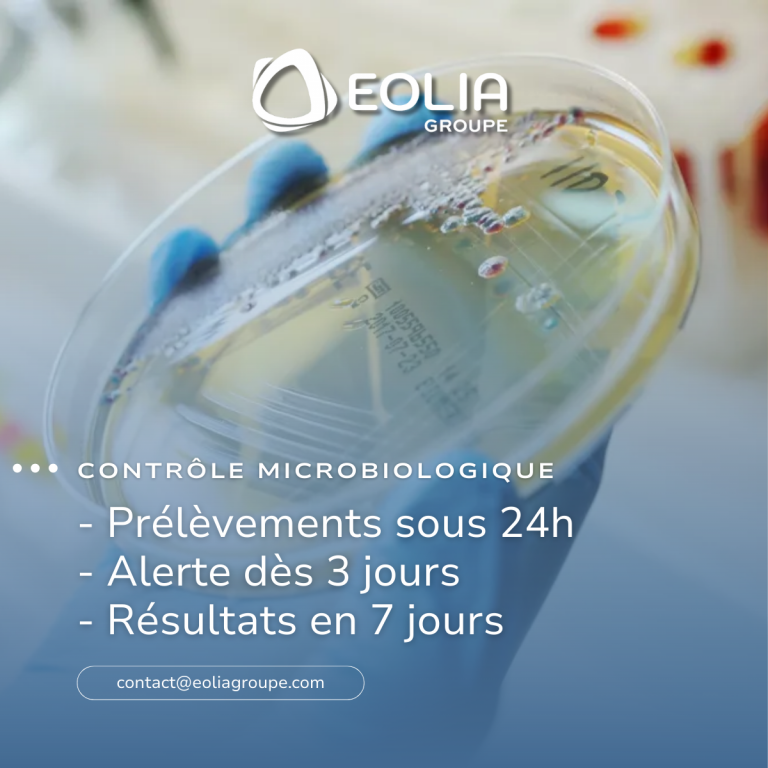

Chez Eolia groupe, nous avons fait le choix d’un laboratoire de microbiologie internalisé pour vous offrir plus de réactivité dans la gestion des risques sanitaires.
Des délais optimisés :
- Prélèvements sous 24 heures
- Résultats complets en 7 jours
- Alerte dès 3 jours en cas de détection de champignons potentiellement pathogènes
Vous anticipez plus tôt, vous limitez les impacts sur votre activité
Un protocole rigoureux et maîtrisé
- Prélèvements microbiologiques de l’air et des surfaces (impaction, sédimentation, écouvillonnage)
- Transport réfrigéré et acheminement des échantillons au laboratoire en moins de 24h
- Incubation selon un double protocole avec lecture intermédiaire et finale
- Identification ciblée des champignons filamenteux (aspergillus / penicillium) en cas de suspicion
Une solution clé en main
- Prélèvement, logistique et analyse en interne
- Suppression des délais liés à la sous-traitance
- Process conforme aux normes en vigueur